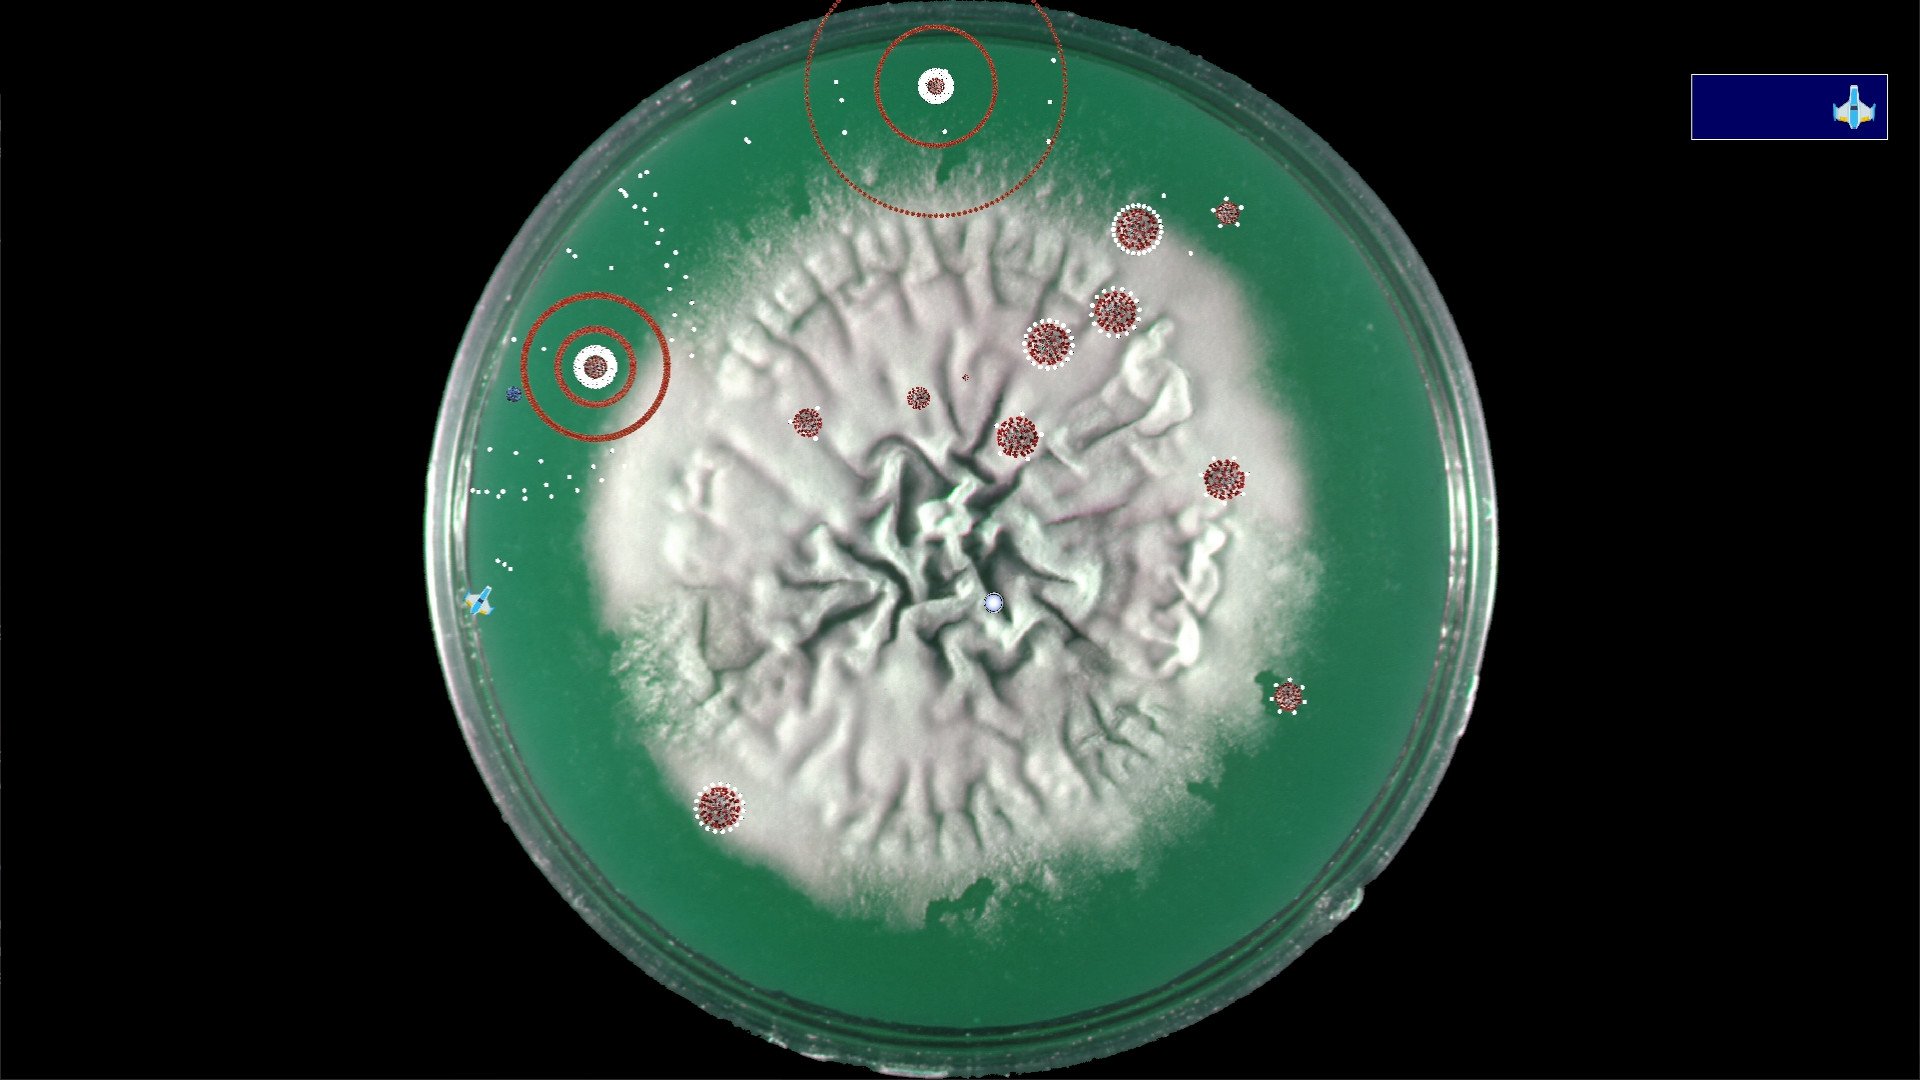
Screenshot

Coronavirus - Nano Force

Details
- Release date: June 25, 2020
- Genre: Action, Arcade, Casual
- Developer: Daniel Snow
- Publisher: Daniel Snow
- Platforms: Steam
Current prices
|
|
Steam
Digital
|
Free
|
Price history
| All time low | |
| Free | |
Description
Train to become a pilot in the newly formed Nano Force. The Nano Force is being formed to aid in the fight against the Coronovius pandemic. Learn to become a nano-pilot so you can help humanity defeat the Coronavirus pandemic!
The game is composed of 5 Training levels and 3 Patient Simulations. The training levels familiarize you with the game, including how the environment works, piloting the ship, the weapons, and powerups. The Patient Simulation levels provide the opportunity to test your skill with increasingly difficult scenarios. The levels all take place in petri dishes, its just for fun.
Leaderboards are maintained for the fastest time to clear each of the Patient Simulation levels, along with Leaderboards for whoever can survive the longest and still clear the level. Challenge yourself by staying at the top of the leaderboards.
Play this game to release your pandemic tension by blasting away at the Coronavirus!